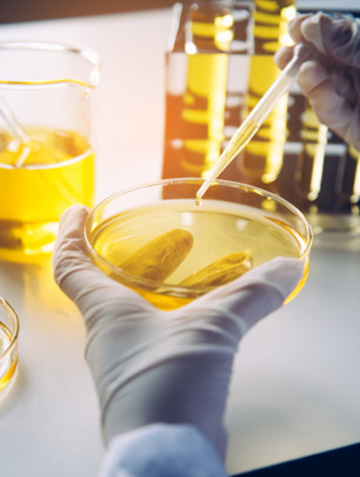

Welcome To BENTON
BENTON BLEACH CHEM PVT. LTD. is an activated bleaching earth production company located on the outskirts of Morbi, an industrial juggernaut of Gujarat state of India. The company is floated and managed by a group of professional entrepreneurs with a deep vision of coming needs and requirements of ever growing Indian markets.
PROCESS

Bentonite Mining
Bentonite is mined from the best bentonite sites in India. The extraction is mechanized, increasing quality output.

Processing
Extracted bentonite is processed in our plant on state of the art machinery and equipment for high performance.
Quality Assurance
In process and end product quality checks are employed to make sure the best bleaching earth is dispatched to our valued customers.

Packaging and Dispatch
Protective quality packaging is carried out to ensure the bleaching clay reaches our customers in great condition.
Keypoints of BENTON
APPLICATIONS
Testimonial
Oil Refiner
Bleaching Earth from Benton delivers more than our expectation
Edible Oil Brand
Benton team has great products but even a greater team to work with
Refinery Entrepreneur
We are more than satisfied to use Benton products. They have great value for money proposition



